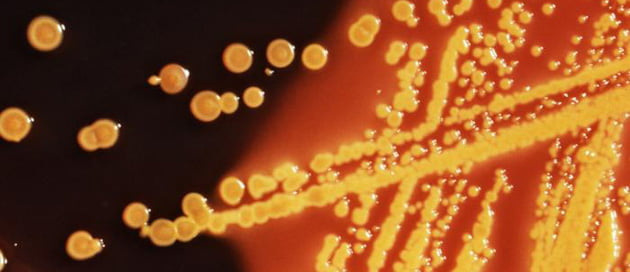

Twee heel gewone bacteriesoorten blijken zich normaal te vermenigvuldigen bij een zwaartekracht 400.000 keer zo groot als die van de aarde.
Wij mensen zijn eigenlijk maar mietjes; al bij krachten van een paar g lopen we kans het bewustzijn te verliezen. Nee, dan de bacteriën die Japanse wetenschappers onderzochten: die werden in een speciale centrifuge zo hard in het rond geslingerd dat ze tienduizenden, zelfs honderdduizenden g’s te verstouwen kregen. En onder die extreme omstandigheden bleven ze niet alleen in leven, maar vermenigvuldigden ze zich zelfs met de gebruikelijke snelheid.
De twee soorten die de hoogste zwaartekracht konden weerstaan (voor wie het heel precies wil weten: 403.627 g), waren Escherichia coli (zie foto) en Paracoccus denitrificans. Allebei bepaald geen exotische organismen; de eerste soort is beter bekend als E. coli en komt veelvuldig voor in de menselijke darmen, terwijl P. denitrificans een vrij gewone bodembacterie is.
Een belangrijke reden voor de ongevoeligheid voor hoge zwaartekracht van dit soort bacteriën is dat ze zo klein zijn. Daarnaast bevatten ze, in tegenstelling tot bijvoorbeeld menselijke cellen, geen celkernen of andere organellen. Die worden dus ook niet bij hoge g-krachten op één hoopje bij elkaar gedrukt, wat ervoor zou zorgen dat ze hun werk niet meer kunnen doen.
Maar dat is niet het hele verhaal. Naast E. coli en P. denitrificans werden namelijk nog een paar andere bacteriesoorten onderzocht, die ‘al’ bij tienduizenden keren de aardse zwaartekracht moesten afhaken. Waar dit verschil in ‘g-kracht-bestendigheid’ vandaan komt, is nog een mysterie.
Bronnen: PNAS, National Geographic
Beeld: CDC